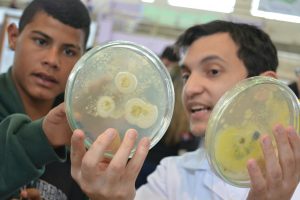

O Instituto de Biociências da Unesp Botucatu já definiu a data para a 13ª edição do Venha Conhecer o IB. O evento será realizado dia 22 de outubro, das 8 às 22 horas, no Espaço IB Eventos.
A iniciativa é direcionada a alunos e professores de escolas de Ensino Médio, públicas e particulares de Botucatu e região. Busca aproximar o público do universo da Ciência e das atividades de ensino, pesquisa e extensão desenvolvidas no IB. A exposição estará dividida em duas grandes áreas: Biodiversidade e Conservação / Sáude e Bem Estar.
Também é uma oportunidade para que jovens em fase de preparação para o vestibular possam conhecer e tirar suas dúvidas em relação aos cursos de graduação oferecidos pela unidade. São eles: Ciências Biológicas, Ciências Biomédicas, Física Médica e Nutrição.
Escolas interessadas em participar do evento, que é gratuíto, podem entrar em contato pelo telefone (14) 3880-0846 ou e-mail [secvicediretoria.ibb@unesp.br] e agendar o horário de visitação.
IB ATENDE MAIS DE MIL ALUNOS
O Instituto de Biociências completa em outubro próximo 56 anos e teve sua origem na então Faculdade de Ciências Médicas e Biológicas (FCMBB). Atende mais de 1.000 alunos de graduação e cerca de 450 alunos de pós-graduação.
Conta com 13 departamentos de ensino: Anatomia, Bioestatística, Botânica, Educação, Farmacologia, Física e Biofísica, Fisiologia, Genética, Microbiologia e Imunologia, Morfologia, Parasitologia, Química e Bioquímica e Zoologia.
Além dos departamentos, integram o IBB três Unidades Auxiliares: Centro de Assistência Toxicológica – Ceatox, Centro de Microscopia Eletrônica – CME e Centro de Isótopos Estáveis – CIE e um Jardim Botânico.
*da assessoria